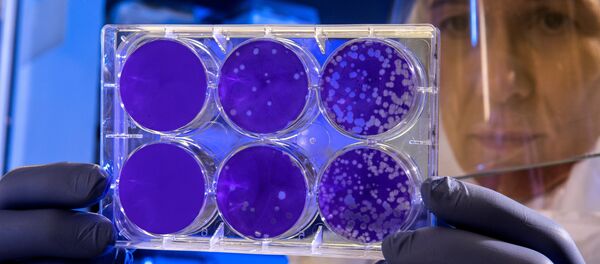
Лаборатория  - Sputnik Аҧсны

АҞӘА, хәажәкыра 24 – Sputnik. Аԥсшьаразы аҭыԥ аанкылара иазку урыстәылатәи асервис Tvil.ru асоциалтә ҳақәа рҿы азҵаара мҩаԥнагеит, иагьеилнакааит ауаа ироуз ааԥынтәи аԥсшьара аамҭазы ԥсшьара иахьцарыз.
Убас, 30 процент аҭаацәарақәа ари ааԥынразы Ҟрымҟа ҳцарын рҳәеит, маҷк инеиҵаны зынӡа џьаргьы ацара рҭахӡам, аҩны иаангылоит, акарантин ршьоит. Ахԥатәи аҭыԥ аҿы игылоуп ақыҭарахь зыуацәа рахь, ма зхатә дачахь ицо аҭаацәарақәа рхыԥхьаӡара.
Аа-процентк раҟара Краснодартәи атәылаҿацә аҟны акоронавирус рҽацәырыхьчарц цәгьа ирбом.
Быжь-процентк аҭаацәарақәа рхәыҷқәа рыманы Аԥсныҟа аара мап ацәыркуамызт.
Ааԥынтәи аԥсшьарамшқәа шәхәыҷқәа шәымны иабашәхыжәгарыз:
• Ҟрым, 30,15%
• Џьаргьы ҳцаӡом, аҩны ҳаанхоит, 28,35%
• Адача/ақыҭара, 12,11%
• Краснодартәи атәылаҿацә, 7,99%
• Аԥсны, 6,7%
• Кавказтәи Аӡы ҵәыҵәқәа, 4,9%
• Баикал, 3,87%
• Карелиа, 3,35%
• Алтаи, 2,06%
• Ленинградтәи аобласт, 0,52%
Аԥсны иахьазы акоронавирус ҿкы аӡәгьы идбалаӡам. Урыстәыла 93,6 нызқьҩык ауааԥсыра акоронавирус рымазар ауеит ҳәа амедицинатә хылаԥшра рзеиҿкаауп.
Иара убас шәаԥхьар ҟалоит:
- Аԥсны асанитар ҳақьым хада акоронавирус зыхьыз ачымазаҩ лзы аинформациа аҿаԥылҽуеит